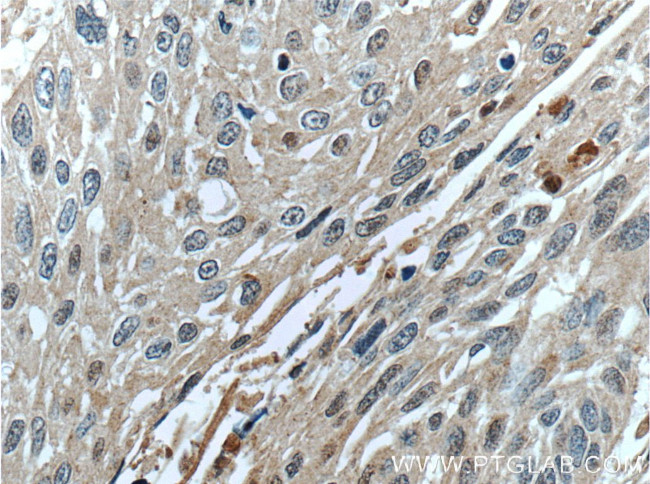
SERPINB8 Antibody in Immunohistochemistry (Paraffin) (IHC (P))

Search
Proteintech
SERPINB8 Polyclonal Antibody
{{$productOrderCtrl.translations['antibody.pdp.commerceCard.promotion.promotions']}}
{{$productOrderCtrl.translations['antibody.pdp.commerceCard.promotion.viewpromo']}}
{{$productOrderCtrl.translations['antibody.pdp.commerceCard.promotion.promocode']}}: {{promo.promoCode}} {{promo.promoTitle}} {{promo.promoDescription}}. {{$productOrderCtrl.translations['antibody.pdp.commerceCard.promotion.learnmore']}}
产品信息
13102-2-AP
种属反应
宿主/亚型
分类
类型
抗原
偶联物
形式
浓度
规格
纯化类型
保存液
内含物
保存条件
运输条件
产品详细信息
Immunogen sequence: MDDLCEANG TFAISLFKIL GEEDNSRNVF FSPMSISSAL AMVFMGAKGS TAAQMSQALC LYKDGDIHRG FQSLLSEVNR TGTQYLLRTA NRLFGEKTCD FLPDFKEYCQ KFYQAELEEL SFAEDTEECR KHINDWVAEK TEGKISEVLD AGTVDPLTKL VLVNAIYFKG KWNEQFDRKY TRGMLFKTNE EKKTVQMMFK EAKFKMGYAD EVHTQVLELP YVEEELSMVI LLPDDNTDLA VKE (1-242 aa encoded by BC034528)
靶标信息
The superfamily of high molecular weight serine proteinase inhibitors. A critical portion of the molecule, the reactive center loop connects beta sheets A and C. Protease inhibitor-8 (PI8; SERPINB8) is a member of the ov-serpin subfamily, which, relative to the archetypal serpin PI1 (MIM 107400), is characterized by a high degree of homology to chicken ovalbumin, lack of N- and C-terminal extensions, absence of a signal peptide, and a serine rather than an asparagine residue at the penultimate position.
仅用于科研。不用于诊断过程。未经明确授权不得转售。
生物信息学
蛋白别名: CAP-2; Cytoplasmic antiproteinase 2; Peptidase inhibitor 8; PI-8; protease inhibitor 8 (ovalbumin type); serine (or cysteine) peptdiase inhibitor, clade B, member 8; serine (or cysteine) proteinase inhibitor, clade B (ovalbumin), member 8; serine (or cysteine) proteinase inhibitor, clade B, member 8; serine protease inhibitor 8; Serpin B8; serpin peptidase inhibitor, clade B (ovalbumin), member 8; unnamed protein product
基因别名: C18orf53; CAP-2; CAP2; NK10; ovalbumin; PI-8; PI8; PSS5; SERPINB8; Spi8
UniProt ID: (Human) P50452, (Mouse) O08800
Entrez Gene ID: (Human) 5271, (Mouse) 20725